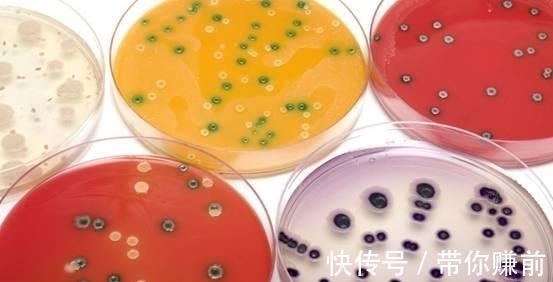
隔夜菜|隔夜菜到底能不能吃?央视为此做实验,结果让人出乎意料

笔者东邪
一年一度的新春佳节即将过去,在中国,几乎每家每户在过年前就屯好了食物,等待整个春节假期的食用,因此春节期间餐桌上总会出现食物吃剩的情况,一些比较节俭的人家会将剩饭剩菜保存下来,留到第二天吃。也有人认为前一天的饭菜留到第二天,这种做法给生命健康造成了不小的隐患。

文章插图
除了存在吃隔夜饭的情况之外,中国还有不少家庭存在喝隔夜茶的情况。而民间传言认为“隔夜茶,毒如蛇”,这句话影响了不少人对隔夜茶的认知。那么隔夜饭和隔夜茶到底能不能吃?它们隔夜后是否会产生对人体有害的物质?下面一起来了解一下。
隔夜饭能吃吗?
隔夜饭一般指的是头一天没吃完的饭菜留到第二天去吃,由于饭菜中存在相对丰富的营养,因此对微生物来说是绝佳的繁殖和生长机会。虽然食材在烹饪过程中受到高温作用几乎将微生物杀死,但菜肴呈上后与空气接触,空气中的微生物又有机会进入到菜肴中。如果隔夜饭保存不妥当,那么菜肴中将可能产生大量微生物,而且可能是致病微生物。

文章插图
根据研究发现,在众多食源性病原体中,有一种名为“李斯特菌”的微生物最为致命。这种细菌取名自医学家约瑟夫·李斯特,它的主要传播途径就是食物,我们几乎可以在任何食物中找到这种微生物的身影,例如常见的肉类、蛋类、蔬菜等。李斯特菌除了分布广之外,还具有环境适应能力强的特点。

文章插图
研究指出,李斯特菌可以在2~42℃的环境中生存,有个别报道指出它海恩那个在0℃的冷藏室里保持较长时间的生长和繁殖。其次,李斯特菌既可以在酸性环境中生存,也可以在碱性环境下生存。国外曾发生过多次严重感染李斯特菌事件,例如上世纪末美国密歇根州就有14人因为食用了被李斯特菌感染的熟肉死亡,其他州共有97人患病,6位妇女因此流产。

文章插图
从2001年1月开始,我国质检部门对来自欧美国家的进口肉类进行多次检查,并从中发现了单增李斯特菌,这是李斯特菌的一个变种,也是分布范围最广的一种。从以往的经验来看,李斯特菌较常出现在肉类中,而中国人的餐桌上几乎是无肉不欢,因此我们需要警惕菜肴中的李斯特菌。
文章插图
除了担心类似李斯特菌这样的致病病原体之外,人们还担心饭菜隔夜后产生对人体具有致癌作用的亚硝酸。研究表明,隔夜饭菜确实会产生亚硝酸盐,但总量并不多,达不到对人体的危害程度。因此隔夜饭并非完全不能吃,但讲究食物的保存方法。如果不对饭菜采取必要的保存措施,那么隔夜饭菜就真的不能吃了。
隔夜茶能喝吗?
说完隔夜饭,再来说说隔夜茶。喝茶是中国人独特的饮食习惯,相信不少朋友出现过在第二天早上因口渴喝了前一天晚上泡的茶的情况,那么隔夜茶一定对人体有害吗?为了探究这个问题,央视栏目还曾经做过一期节目,节目中设立了龙井、普洱和菊花茶,分别泡了一壶隔夜茶,然后让高级品茶师进行品尝。

文章插图
根据品茶师的描述,隔夜茶并没有出现馊味,茶该有的味道还保留着,而且普洱茶隔夜后口感更胜一筹。口感上是没太大影响,那对人体健康有影响吗?为了弄清楚这个问题,栏目组将隔夜茶送进实验室进行成分测量,发现其中的确存在亚硝酸盐,但亚硝酸盐的含量低于饮用水的卫生标准。

文章插图
由此说明“隔夜茶,毒如蛇”的说法是不成立的,但专家表示隔夜茶也需要得到妥当的保存才能喝,如果直接暴露在空气中,除了会受到空气中的微生物的影响之外,还会受到其他生物的影响,例如老鼠、蚊子、苍蝇等。
【 隔夜菜|隔夜菜到底能不能吃?央视为此做实验,结果让人出乎意料】总结
综上所述,隔夜饭和隔夜茶并非完全不能食用和饮用,前提是饭菜和茶水在保存前没有变质,而且得到妥善的保存。说到食物的保存,不少人认为饭菜要放凉了才能放入冰箱,但这种做法其实是错误的,相当于给微生物生长和繁殖的机会。饭菜在逐渐冷却的过程中,其中的微生物反而逐渐活跃起来,等到饭菜完全放冷了,里面的微生物浓度也就达到了峰值。
- 蒲公英|女人养肝就是抗衰老,3种野菜,养肝护肝,肝脏舒服,人才显年轻
- 牛肉|孩子长身体,多做给孩子吃的两道菜,补充营养强壮体质学习好
- 荤香味|入秋后才会有的野菜,可以治风湿痛、关节炎,遇见了一定要带回家
- 原生态|山间野菜太多,一会功夫就摘一背篓,拿回家可以做成特色美味小吃
- 红血丝|眼睛经常有红血丝常吃此菜可清肝明目,改善目赤肿痛和多泪
- 韭菜|明日雨水,再忙也别忘吃“3菜2果1豆”,应季而食,助你安然度春
- 补钙补蛋白|孩子抵抗差易生病,多吃的菜,补钙补蛋白,强健筋骨,增强抵抗力
- 血红素铁|铁锅炒菜能补铁?关于补铁的那些事,可能你未必搞清楚
- 爱马仕|蔬菜中的“爱马仕”,健脾清热,但吃时少做这一步,致癌风险很大!
- 蘑菇|隔夜的菜究竟能不能吃?忠言劝告:三种隔夜菜别吃,扔掉不可惜
